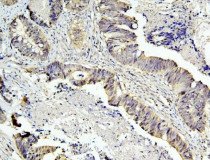

ARG43230
anti-Caspase 3 antibody [8B6]
anti-Caspase 3 antibody [8B6] for Flow cytometry,IHC-Formalin-fixed paraffin-embedded sections,Western blot and Human
Cancer antibody; Cell Biology and Cellular Response antibody; Cell Death antibody; Neuroscience antibody; Apoptosis Marker antibody; Mitochondria/Caspase Dependant Apoptosis Marker antibody
概述
| 产品描述 | Mouse Monoclonal antibody [8B6] recognizes Caspase 3 |
|---|---|
| 反应物种 | Hu |
| 应用 | FACS, IHC-P, WB |
| 宿主 | Mouse |
| 克隆 | Monoclonal |
| 克隆号 | 8B6 |
| 同位型 | IgG1 |
| 靶点名称 | Caspase 3 |
| 抗原物种 | Human |
| 抗原 | Recombinant protein corresponding to T67-D175 of Human Caspase 3. |
| 偶联标记 | Un-conjugated |
| 別名 | CASP3; Caspase 3; Apopain; CPP32; CPP32B; Caspase 3, Apoptosis-Related Cysteine Peptidase; Caspase 3, Apoptosis-Related Cysteine Protease; SREBP Cleavage Activity 1; Cysteine Protease CPP32; Protein Yama; EC 3.4.22.56; Caspase-3; CASP-3; CPP-32; SCA-1; Yama; PARP Cleavage Protease; Procaspase3; EC 3.4.22 |
应用说明
| 应用建议 |
|
||||||||
|---|---|---|---|---|---|---|---|---|---|
| 应用说明 | IHC-P: Antigen Retrieval: Heat mediation was performed in EDTA buffer (pH 8.0). * The dilutions indicate recommended starting dilutions and the optimal dilutions or concentrations should be determined by the scientist. |
||||||||
| 实际分子量 | ~ 35 kDa |
属性
| 形式 | Liquid |
|---|---|
| 纯化 | Affinity purification with immunogen. |
| 缓冲液 | 0.2% Na2HPO4, 0.9% NaCl, 0.05% Sodium azide and 4% Trehalose. |
| 抗菌剂 | 0.05% Sodium azide |
| 稳定剂 | 4% Trehalose |
| 浓度 | 0.5 mg/ml |
| 存放说明 | For continuous use, store undiluted antibody at 2-8°C for up to a week. For long-term storage, aliquot and store at -20°C or below. Storage in frost free freezers is not recommended. Avoid repeated freeze/thaw cycles. Suggest spin the vial prior to opening. The antibody solution should be gently mixed before use. |
| 注意事项 | For laboratory research only, not for drug, diagnostic or other use. |
生物信息
| 数据库连接 | |
|---|---|
| 基因名称 | CASP3 |
| 全名 | caspase 3, apoptosis-related cysteine peptidase |
| 背景介绍 | The protein encoded by this gene is a cysteine-aspartic acid protease that plays a central role in the execution-phase of cell apoptosis. The encoded protein cleaves and inactivates poly(ADP-ribose) polymerase while it cleaves and activates sterol regulatory element binding proteins as well as caspases 6, 7, and 9. This protein itself is processed by caspases 8, 9, and 10. It is the predominant caspase involved in the cleavage of amyloid-beta 4A precursor protein, which is associated with neuronal death in Alzheimer's disease. [provided by RefSeq, Aug 2017] |
| 生物功能 | Cleaves XRCC4 and phospholipid scramblase proteins XKR4, XKR8 and XKR9, leading to promote phosphatidylserine exposure on apoptotic cell surface. [UniProt] |
| 细胞定位 | Cytoplasm. [UniProt] |
| 产品亮点 | Related Antibody Duos and Panels: ARG30105 Apoptosis Marker Antibody Duo (Caspase3, PARP) ARG30110 Mitochondria/Caspase dependant Apoptosis Antibody Panel (Caspase3, Caspase9, Cytochrome c, PARP) (WB) Related products: Caspase 3 antibodies; Caspase 3 Duos / Panels; Anti-Mouse IgG secondary antibodies; |
| 研究领域 | Cancer antibody; Cell Biology and Cellular Response antibody; Cell Death antibody; Neuroscience antibody; Apoptosis Marker antibody; Mitochondria/Caspase Dependant Apoptosis Marker antibody |
| 预测分子量 | 32 kDa |
| 翻译后修饰 | Acetylation, Phosphoprotein, S-nitrosylation, Zymogen. [UniProt] |
检测图片 (5) Click the Picture to Zoom In
-
ARG43230 anti-Caspase 3 antibody [8B6] IHC-P image
Immunohistochemistry: Paraffin-embedded Human tonsil tissue. Antigen Retrieval: Heat mediation was performed in EDTA buffer (pH 8.0). The tissue section was blocked with 10% goat serum. The tissue section was then stained with ARG43230 anti-Caspase 3 antibody [8B6] at 1 µg/ml dilution, overnight at 4°C.
-
ARG43230 anti-Caspase 3 antibody [8B6] WB image
Western blot: 50 µg of sample under reducing conditions. Human placenta, K562, HepG2 and Raji whole cell lysates stained with ARG43230 anti-Caspase 3 antibody [8B6] at 0.5 µg/ml dilution, overnight at 4°C.
-
ARG43230 anti-Caspase 3 antibody [8B6] FACS image
Flow Cytometry: HepG2 cells were blocked with 10% normal goat serum and then stained with ARG43230 anti-Caspase 3 antibody [8B6] (blue) at 1 µg/10^6 cells for 30 min at 20°C, followed by incubation with DyLight®488 labelled secondary antibody. Isotype control antibody (green) was mouse IgG (1 µg/10^6 cells) used under the same conditions. Unlabelled sample (red) was also used as a control.
-
ARG43230 anti-Caspase 3 antibody [8B6] IHC-P image
Immunohistochemistry: Paraffin-embedded Human intestinal cancer tissue. Antigen Retrieval: Heat mediation was performed in EDTA buffer (pH 8.0). The tissue section was blocked with 10% goat serum. The tissue section was then stained with ARG43230 anti-Caspase 3 antibody [8B6] at 1 µg/ml dilution, overnight at 4°C.
-
ARG43230 anti-Caspase 3 antibody [8B6] IHC-P image
Immunohistochemistry: Paraffin-embedded Human placenta tissue. Antigen Retrieval: Heat mediation was performed in EDTA buffer (pH 8.0). The tissue section was blocked with 10% goat serum. The tissue section was then stained with ARG43230 anti-Caspase 3 antibody [8B6] at 1 µg/ml dilution, overnight at 4°C.